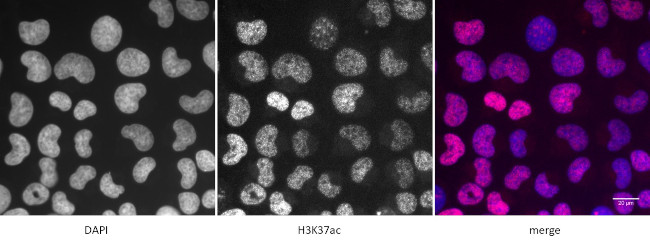
Histone H3K37ac Antibody in Immunocytochemistry (ICC/IF)

Search
Active Motif
Histone H3K37ac Polyclonal Antibody
{{$productOrderCtrl.translations['antibody.pdp.commerceCard.promotion.promotions']}}
{{$productOrderCtrl.translations['antibody.pdp.commerceCard.promotion.viewpromo']}}
{{$productOrderCtrl.translations['antibody.pdp.commerceCard.promotion.promocode']}}: {{promo.promoCode}} {{promo.promoTitle}} {{promo.promoDescription}}. {{$productOrderCtrl.translations['antibody.pdp.commerceCard.promotion.learnmore']}}
产品信息
61587
种属反应
已发表种属
宿主/亚型
分类
类型
抗原
偶联物
形式
浓度
纯化类型
保存液
内含物
保存条件
运输条件
RRID
靶标信息
Histone H3 is one of the DNA-binding proteins found in the chromatin of all eukaryotic cells. H3 along with four core histone proteins binds to DNA forming the structure of the nucleosome. Histones play a central role in transcription regulation, DNA repair, DNA replication and chromosomal stability. Post translationally, histones are modified in a variety of ways to either directly change the chromatin structure or allow for the binding of specific transcription factors. The N-terminal tail of histone H3 protrudes from the globular nucleosome core and can undergo several different types of post-translational modifications that influence cellular processes. These modifications include the covalent attachment of methyl or acetyl groups to lysine and arginine amino acids and the phosphorylation of serine or threonine.
仅用于科研。不用于诊断过程。未经明确授权不得转售。
生物信息学
蛋白别名: Acetyl H3; Acetyl Histone 3; Acetyl Histone H3; H3; H3 histone family, member A; H3 histone family, member I; H3 histone family, member K; H3 histone family, member M; H3 histone, family 2; H3-clustered histone 13; H3-clustered histone 14; H3-clustered histone 15; HIST1H3A; HIST1H3F; histone 1, H3a; histone 1, H3f; histone 1, H3h; histone 2, H3a; histone 2, H3c; Histone 3; histone cluster 1 H3 family member a; histone cluster 1 H3 family member f; histone cluster 1 H3 family member h; histone cluster 1, H3a; histone cluster 1, H3f; histone cluster 1, H3h; histone cluster 2 H3 family member a; histone cluster 2 H3 family member c; histone cluster 2, H3a; histone cluster 2, H3c; Histone H3; Histone H3.1; Histone H3.2; Histone H3/a; Histone H3/b; Histone H3/c; Histone H3/d; Histone H3/f; Histone H3/h; Histone H3/i; Histone H3/j; Histone H3/k; Histone H3/l; Histone H3/m; Histone H3/o; unnamed protein product
基因别名: H3; H3.2; H3/A; H3/i; H3/k; H3/M; H3/n; H3/o; H3C1; H3C10; H3C11; H3C12; H3C13; H3C14; H3C15; H3C2; H3C3; H3C4; H3C6; H3C7; H3C8; H3F1K; H3F2; H3FA; H3FB; H3FC HIST1H3C; H3FD; H3FF; H3FH; H3FI; H3FJ; H3FK; H3FL; H3FM; H3FN; HIST1H3A; HIST1H3B; HIST1H3D; HIST1H3E; HIST1H3F; HIST1H3G; HIST1H3H; HIST1H3I; HIST1H3J; HIST2H3A; HIST2H3C; HIST2H3D
UniProt ID: (Human) P68431, (Human) Q71DI3
Entrez Gene ID: (Human) 8350, (Human) 8357, (Human) 126961, (Human) 333932, (Human) 8968